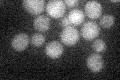
YLR205C
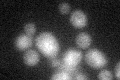
YLR205C
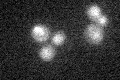
YLR205C

View description
ER localized, heme-binding peroxidase involved in the degradation of heme; does not exhibit heme oxygenase activity despite similarity to heme oxygenases; expression regulated by AFT1
Localization:
Intensity:
Fold change:
Significance:
-
C’ GFP library in SD
below threshold18.04 -
N' NOP1pr-GFP in SD

N/A0 -
N' TEF2pr-mCherry in SD

N/A0 -
N' NATIVEpr-GFP in SD

N/A0 -
N' TEF2pr-VC and Cyto-VN in SD

N/A0 -
C’ GFP library in SD+DTT
cytosol19.461.07No -
C’ GFP library in SD+H2O2

cytosol22.961.27No -
C’ GFP library in Starvation Media
cytosol18.931.04No -
C’ GFP library on the background of Pup2-DaMP

below threshold -
C’ GFP library on the background of CCT mutant

below threshold19.81921.09766No
